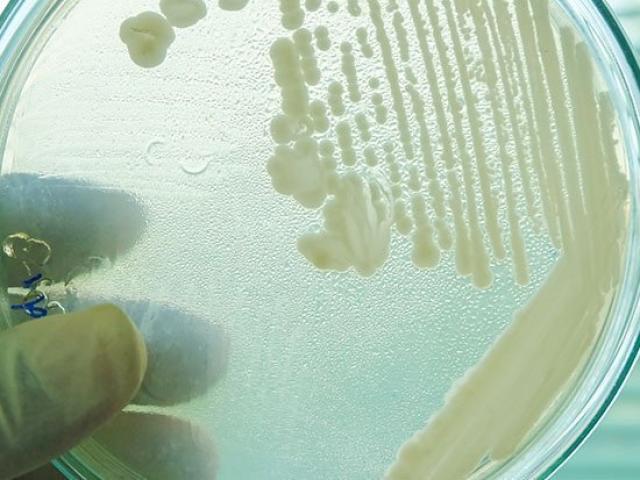
Sức khỏe đời sống - Siêu nấm “giết người” đang lan rộng khắp thế giới

Loại quả là "thần dược" chống ung thư, tăng ham muốn "phòng the"
Ít ai ngờ rằng quả xoài, loại trái cây quen thuộc lại có tác dụng như 'thần dược' đối với nhiều bệnh tật nguy hiểm như chống ung thư, tăng cường miễn dịch, kiểm soát huyết áp, bảo vệ tim, tăng ham muốn tình dục...
Ảnh minh hoạ: Internet
Một cốc sinh tố xoài chứa 103 kalo, 75% vitamin C có tác dụng chống ôxy hóa và tăng cường hệ miễn dịch; 24% vitamin A giúp chống oxy hóa và tăng thị lực; 12% vitamin B6 và một số vitamin B khác các tác dụng phòng bệnh não và tim; 10% lợi khuẩn; 8% đồng cần cho việc sản xuất các tế bào máu; 8% kali giúp cân bằng lượng natri trong cơ thể và 5% magie.
Hàm lượng lớn vitamin A và vitamin C trong trái xoài, cộng với 26 loại carotenoids khác nhau có tác dụng duy trì sự bền vững và khỏe mạnh của hệ thống miễn dịch.
Xoài chứa vitamin B6, giúp củng cố hỗn hợp dẫn truyền thần kinh có tác dụng xác định tâm trạng và tạo lập giấc ngủ.
Xoài có chứa beta-caroten, chất có nhiều trong cà rốt, giúp tăng cường hệ thống miễn dịch của cơ thể. Beta-caroten được chuyển hóa thành vitamin A giúp bảo vệ cơ thể khỏi bệnh tật và các gốc phân tử tự do.
Tăng cường miễn dịch
Theo các bác sĩ, một quả xoài cỡ bình thường có nhiều dinh dưỡng hơn bơ hoặc hạnh nhân. Nó tăng cường và kích thích tất cả các dây thần kinh, mô và cơ trong não não, tim và các bộ phận khác của cơ thể. Nó cũng làm sạch cơ thể từ bên trong và tăng cường miễn dịch.
Ảnh minh hoạ: Internet
Phòng tránh ung thư
Xoài rất giàu chất xơ, vitamin, khoáng chất và các flavonoid đa phenolic (thành phần chống oxy hóa). Xoài có thể bảo vệ chống một số loại ung thư như ung thư đại tràng, vú và ung thư tuyến tiền liệt cũng như bệnh bạch cầu.
Giúp duy trì thị lực
Xoài chứa nhiều vitamin A và các flavonoid như beta-carotene, alpha-carotene va beta-cryptoxanthin. Những hợp chất này có thể giúp cải thiện và duy trì thị lực. Hàm lượng caroten trong loại quả này giúp bảo vệ cơ thể khỏi ung thư phổi.
Kiểm soát huyết áp
Xoài chứa nhiều kali. Các nhà dinh dưỡng cho biết 100 g loại quả này cung cấp 156mg kali và chỉ 2mg natri. Kali là một thành phần quan trọng của tế bào và dịch cơ thể. Nó cũng giúp kiểm soát nhịp tim và huyết áp.
Cải thiện làn da
Chứa nhiều vitamin A, xoài cung cấp cho cơ thể dưỡng chất cần thiết để duy trì làn da khỏe mạnh.
Ảnh minh hoạ: Internet
Bảo vệ bạn khỏi bệnh tim
Xoài cũng chứa nhiều vitamin B6 (pyridoxine), vitamin C và vitamin E. Vitamin C giúp cơ thể phát triển sức đề kháng chống lại nhiễm trùng và loại bỏ các gốc tự do gây hại. Vitamin B6 hoặc pyridoxine là cần thiết để sản sinh hormon GABA (loại hormon cần thiết để duy trì cơ bắp) trong não. Nó cũng giúp kiểm soát hàm lượng homocystiene trong máu, nó có thể giúp bảo vệ tránh bệnh động mạch vành và đột quỵ.
Ngăn ngừa thiếu máu
Loại quả này chứa một lượng đồng vừa phải. Đồng là một yếu tố cần thiết để các enzym hoạt động thích hợp, bao gồm cytochrome c-oxidase và superoxide dismutase. Đồng cũng cần thiết cho việc sản sinh các tế bào hồng cầu.
Kiểm soát cholesterol
Xoài chứa hàm lượng vitamin C, pectin và chất xơ cao giúp giảm hàm lượng cholesterol huyết thanh. Xoài tươi giàu kali, là thành phần cần thiết của tế bào và dịch cơ thể. Nó giúp kiểm soát nhịp tim cũng như huyết áp.
Ảnh minh hoạ: Internet
Giảm cân
Xoài chứa nhiều vitamin và khoáng chất sẽ giúp bạn cảm thấy no lâu hơn. Ngoài ra, loại quả giàu chất xơ này cũng giúp đốt cháy nhiều calo và hỗ trợ giảm cân.
Kích thích tình dục
Xoài được cho là có chất kích thích tình dục, làm khả năng tình dục của nam giới. Vitamin E giúp điều chỉnh hormon giới tính và cũng làm tăng cường ham muốn tình dục.
Hỗ trợ tiêu hóa
Xoài chứa các enzym nhất định giúp phá vỡ protein. Chất xơ của loại trái cây này giúp điều chỉnh tiêu hóa và bài tiết..
Ảnh minh hoạ: Internet
Chống say nắng
Uống nước ép xoài sẽ giúp làm mát cơ thể ngay tức khắc cũng như ngăn ngừa say nắng
Tẩy da chết
Trộn hỗn hợp xoài, mật ong và sữa. Dùng hỗn hợp này như một hỗn hợp tẩy da chết. Bạn sẽ có làn da mịn màng, mềm mại.
Hải sản là nguồn thực phẩm tráng dương được chứng minh từ lâu đời, đặc biệt với những quý ông có “trục trặc...